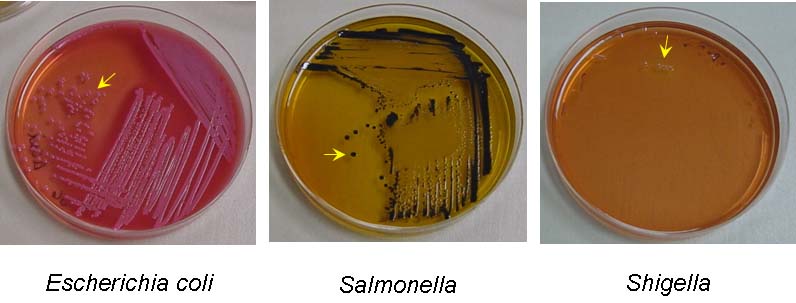

Salmonella-Shigella plates
Salmonella-Shigella (SS) plates are used to detect bacterial contamination on raw meat. Salmonella-Shigella agar plates contain lactose, bile salts, ferric citrate, and neutral red. The bile salts select for Gram-negative bacteria. The other components differentiate among Gram-negative bacteria.
Coliform bacteria such as E. coli will ferment the lactose in the media, resulting in bacterial growth with a pink color. (They do not produce any hydrogen sulfide.) Members of the genus Salmonella will not ferment lactose, but do product hydrogen sulfide gas. The resulting bacterial colonies will appear colorless with black centers. Members of the genus Shigella do not ferment lactose or produce hydrogen sulfide gas, so the resulting colonies will be colorless.